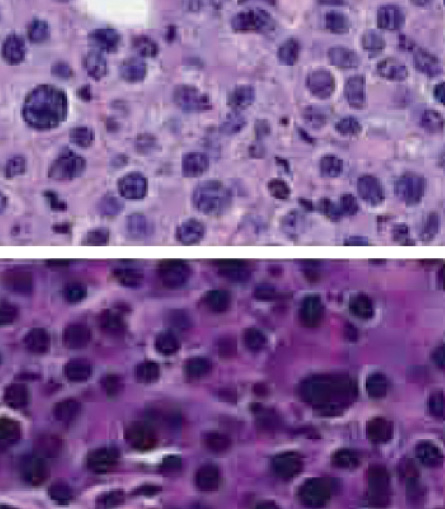

It looked like a lost cause: a 61-year-old patient with advanced pancreatic cancer — one of the deadliest diagnoses. Ordinarily, doctors wouldn’t have much choice. They could try chemotherapy drugs one at a time to see if any worked, or they could slam the tumor with a cocktail of chemicals that had shown some success with similar cases.

But this time the doctors had another option: trying out potential treatments on mice. These weren’t run-of-the-mill lab rodents, though. Scientists had created 17 mice with an immune system matched to the patient’s. After growing “copies” of the patient’s cancer in the mice, doctors tried a slew of different treatments on the tumors and discovered that the cancer was extremely sensitive to one particular drug.
Scientists had implanted human tumors in mice before. But there was no guarantee that mice would respond to drugs the way a person would. In the new approach, young mice engineered to lack immune systems receive transplants of portions of a patient’s immune system. As the mice mature, they develop a humanlike immune response to drugs or infectious agents.
“The idea is that you can take human immune systems and put them in a mouse and make them functional. Then you can manipulate them as if you were manipulating little humans, so to speak, without ever putting patients at risk,” says Dale Greiner of the University of Massachusetts Medical School.
Such “humanized” mice may not be able to dance, drive cars or play chess like a human. But they might soon help doctors predict how people will respond to a particular treatment or warn of deadly side effects in new medicines before they go on the market.
The day your local doctor can grow a colony of mice with your immune system and particular ailment is still years away, but the scenario gets more plausible every week. Already, for dozens of cancer patients, the mice have helped identify potential treatments before therapy began. And at the University of California, Davis, scientists are using such mice to test a new kind of bladder cancer treatment. That treatment is now moving toward human clinical trials.
Cancer is only one area where humanized mice may be useful. Studies now under way are using the mice as stand-ins to see how the immune system responds to infectious agents such as dengue virus or HIV. Other research uses humanized mice to learn how complex diseases such as rheumatoid arthritis and diabetes operate. In his own lab, Greiner studies the immune system in hyperglycemic mice to shed light on the development of type 1 diabetes, an autoimmune disease.
Man or mouse?
Medical researchers have always relied on animal tests to see how cells and organs react to infections or drugs. Such tests would be hazardous and unethical to perform on people.
But animal anatomies are not the same as human bodies. There is no animal that gets acquired immune deficiency syndrome in the same way humans do, for example. For years, the rhesus monkey has served as the animal alternative for HIV research, but in most cases the monkey can be infected only with a related virus. Differences in the viruses, along with differences between the human and monkey immune systems, limit studies designed to understand HIV or to test drugs and vaccines.
Humanized mice, however, respond to HIV more like a man than a mouse, researchers reported last July in Science Translational Medicine. A group led by Todd Allen of Harvard Medical School showed how the virus mutates and attempts to evade these responses just as it does in humans.
“For the first time we have an animal model that accurately reproduces these critical host-pathogen interactions,” Allen says. His lab at the Ragon Institute (a joint venture of Harvard, MIT and the Massachusetts General Hospital) is now using the mice to see how human immune responses might succeed or fail to control HIV. His ultimate goal is to find an effective HIV vaccine.
To get a mouse to mount a humanlike immune response is no easy feat. Normally, mice are immune to many of the infectious agents that make humans sick. That’s because many aspects of a mammal’s immune system are designed to fight off specific types of invaders that vary from species to species. One form of a flu virus, for example, plagues dogs, while other types affect birds, horses and humans.
Despite these differences, all mammals have immune systems that are divided into two categories: the innate system and the adaptive system. Innate immunity is present in all animals, providing immediate but short-lived relief. As the first line of defense against bacteria and viruses, innate immune cells take a broad-based, slug-it-out approach to immunity, mounting a defense against any agent that appears “foreign.”
“It’s like putting up a flypaper stick in the window and anything that flies by gets stuck,” says Greiner.
Adaptive immunity, by contrast, is exquisitely specific and much more complex. It produces long-lasting protection against specific pathogens after an initial exposure. Vaccines, for example, work because the body generates antibody responses and cellular responses that are capable of targeting a specific molecule.
One way to get around these defenses is to wipe out the mouse’s own adaptive immune system. Another more common practice is to work with mice that have no such system. Years ago, scientists discovered a strain of mice with a genetic defect that prevents their immune system from developing, leaving them defenseless against all environmental microbes and infectious agents. Called severe combined immunodeficient mice, or SCID mice, they have the equivalent of what is known as “bubble boy” disease. Because their bodies’ defenses are almost totally absent, the mice do not reject foreign tissue.
In 1988, two research groups successfully used SCID mice to create a small, working model of a human immune system. One group transplanted tissue taken from the liver, thymus and lymph glands of fetuses. The other team injected human white blood cells into the mice. Both types of transplants produced mice with human immune system cells and antibodies.
In the early 1990s, scientists developed a way to get human blood stem cells into the mice. Such cells, isolated from blood or bone marrow, can renew themselves and differentiate into various cell types. In 1995, Leonard Shultz and his group at the Jackson Laboratory in Bar Harbor, Maine, created an improved strain called the NOD/SCID mouse, which allowed more types of human cells to grow when engrafted in mice.
NOD/SCID mice offered another advantage: They could generate most of the disease-fighting components of the human immune system, with the important exception of T cells. T cells attack invaders directly, looking for them by recognizing distinctively shaped structures on their coats. In 2004, scientists at the Institute for Research in Biomedicine in Switzerland found a way to get T cells to develop from stem cells in mice. The following year, Shultz and his team found that disabling a gene called interleukin-2 receptor gamma also enabled T cell development. With robust T cells, the mice could help scientists study how the human body fights disease.
Since then, humanized mice have been tweaked to become an even friendlier host to human cells. Today, three main “brands” of mouse strains are used in laboratories around the world. The NOG mouse, developed by Mamoru Ito of the Central Institute for Experimental Animals in Japan; the BRG mouse, developed in Switzerland; and the NSG mouse, developed and distributed by the Jackson Laboratory. Some support high levels of T cells, while others allow engraftment of bone marrow or other particular tissue types. Scientists select a strain based on their needs.
Over the last few years the mice have been adapted as tools to study human biological processes in a wide range of fields. In regenerative medicine, for example, scientists looking for ways to replace damaged tissues such as muscle, liver or nerve cells are placing human stem cells in the mice to see how the cells function. Researchers figure if the stem cells can repair some kind of damage in the humanized mice, chances are they will work in a person as well.
Other studies focus on infectious disease, using humanized mice as guinea pigs to forecast how humans will respond when infected with agents such as dengue virus, typhoid fever or HIV.
Personalized treatments
Physicians, too, are latching onto the humanized mice, using them as “avatars” for real people. These avatars can help doctors find the most effective cocktail of cancer drugs to combat a particular tumor before treating a patient.
Traditionally, doctors follow a course of treatment based on tumor type. That’s likely to change as more studies show how humanized mice can help tailor treatment to the individual, says Manuel Hidalgo of the Spanish National Cancer Research Center in Madrid.
Hidalgo and his collaborators identified life-extending treatments for 11 out of 14 cancer patients after developing colonies of mice customized for each person. (One patient died before treatment began, and in two cases, the tumors simply did not grow in the mice). In each case, the drug activity in the mice matched the outcome for the patients, the team reported in Molecular Cancer Therapeutics in 2011.
“Every time we saw a response in the mouse, we later saw it in the patient. If there was no response, we didn’t see it in the patient,” says study coauthor David Sidransky, an oncologist at the Johns Hopkins School of Medicine.
Since then, Hidalgo, Sidransky and their colleagues have used avatar mice in a larger study to analyze response rates in more than 60 patients. The mice successfully identified treatment options for 94 percent of the patients. In some of those cases, the mice predicted that there was no treatment available, and indeed, attempts to treat those patients failed.
“The beauty of the grafts is that they allow you to test any kind of drug in any kind of combination,” Sidransky says. “You can line up 100 mice with that tumor and try every concoction you want to throw at it to see if one will work…. Standard tests just allow you to look at one drug at a time, and give you a very limited scenario for what you can do.”
In their initial study, Sidransky and Hidalgo found treatments that worked in the mouse tumor that would have otherwise been overlooked because they were not considered “standard care” for those tumor types. One such serendipitous finding helped extend the life of the 61-year-old pancreatic cancer patient. After engrafting pieces of the patient’s tumor onto 17 mice and trying a score of different treatments, the scientists discovered that the tumor was extremely sensitive to a drug called mitomycin C. When treated with this drug, the patient’s tumor went into remission and he went on to live for nearly seven years.
Later, Hidalgo and his group performed a genetic analysis on that patient’s tumor and found that it contained a mutation that made the cancer susceptible to that particular drug. Those findings were published in a separate 2011 paper in Molecular Cancer Therapeutics. The group is now using an approach that combines genomic analysis with the avatar models. That means that while the tumors are growing in the mice, the scientists can look at genetic features of the patient’s cancer — helping to zero in on potential therapies faster.
Besides their use in tailoring known treatments to patients, avatar mice are also test-driving entirely new approaches to chemotherapy. At UC Davis, Chong-Xian Pan has transplanted tumors from bladder cancer patients directly into NSG mice to test a new type of drug delivery system. Generally, tumor cells taken from patients are cultured in a laboratory dish before implantation in a mouse. Or, as is often done when testing new drugs, researchers draw on cell lines that have been grown in the lab for years or even decades.
“Cancer cells are not very stable and easily mutate, so the cell lines most likely are different from those in the patient,” Pan says.
After placing tumor cells directly into mice, Pan and his team were able to deliver higher doses of anticancer drugs directly to the cancer cells, without upping toxicity. The new therapy, outlined recently in Nanomedicine, will soon move into clinical trials, testing the first new approach to treating bladder cancer in nearly three decades, Pan says.
They’re only human
Even though human trials are moving forward for some types of cancer, the humanized mouse has its limits. Not all tumor types grow in the humanized mice. Breast cancer, for example, generally won’t take hold. But the main drawback to the system is time, Hidalgo says. It takes four to six months for a colony of mice to grow the tumors and to test how the cancers respond to treatment. So the mice may not be useful for people with primary, easily treatable tumors. But for those who have relapsed and run out of options, the mouse avatar may provide useful, and life-saving, insights.
“It’s a good model, if you have everything in place,” Hidalgo says. “The ideal situation is to get the study going very early so that by the time the patient’s cancer has become resistant to standard treatment, you have new targets on hand.”
Meanwhile, researchers continue to tweak the mice to make them even more humanlike. So far, no single mouse can fully replicate a human immune system. And some human immune cells are killed off by proteins made by the mice. As those killer proteins are identified, scientists are working to find ways to disable them.
Scientists also hope to develop strains that include human features beyond the immune system, such as liver cells. Because mice metabolize some drugs differently from the way people do, adding a human liver would allow researchers to test the toxicity of candidate drugs before going to human trials.
“Humans are not mice, so you need to see how the immune cells respond in a system with living human cells,” Greiner says. “These mice allow that opportunity.”
Mouse milestones
The effort to remake mice to more closely resemble humans in their response to disease began with mice that were missing their own functional immune system. Genetic engineering has allowed further refinements of these mice to enhance the establishment of human immune cells.
1966: Scientists discover a strain of mice, called “nude” mice, with a genetic defect that prevents their immune system from developing. This defect results from a mutation in a single gene. Scientists later discover that the nude mouse lacks a functioning thymus, a gland that plays a key role in immune development.
1983: Scientists discover a mouse strain that lacks both T cells and B cells, and other components of the immune system. This defect results from two flawed copies of a gene and is known as severe combined immunodeficiency, or SCID. Mice with this mutation are ideal for scientific research as they will not reject transplanted foreign tissue.
1988: Two different research groups implant major parts of the human immune system into SCID mice. One group engrafts tissue taken from the liver, thymus and lymph glands into the mice. The other team injects mature immune cells that circulate in the blood (white blood cells) into the animals. Both sets of mice produce some human immune cells and antibodies.
1992–1995: Researchers find a way to get human blood stem cells into the mice. Because stem cells can give rise to the full array of immune cells, this allows more types of human cells to grow when engrafted into mice. In addition, it helps the mice to generate more components of the human immune system, though they still can’t produce T cells.
2004–2005: Scientists spur human T cell development in mice by disabling a human gene called IL-2 receptor gamma along with blood stem cells. With working T cells, the mice can be used to study how the human body fights disease.
Today: Mice with a near-complete array of human immune cells are used to study a variety of diseases.